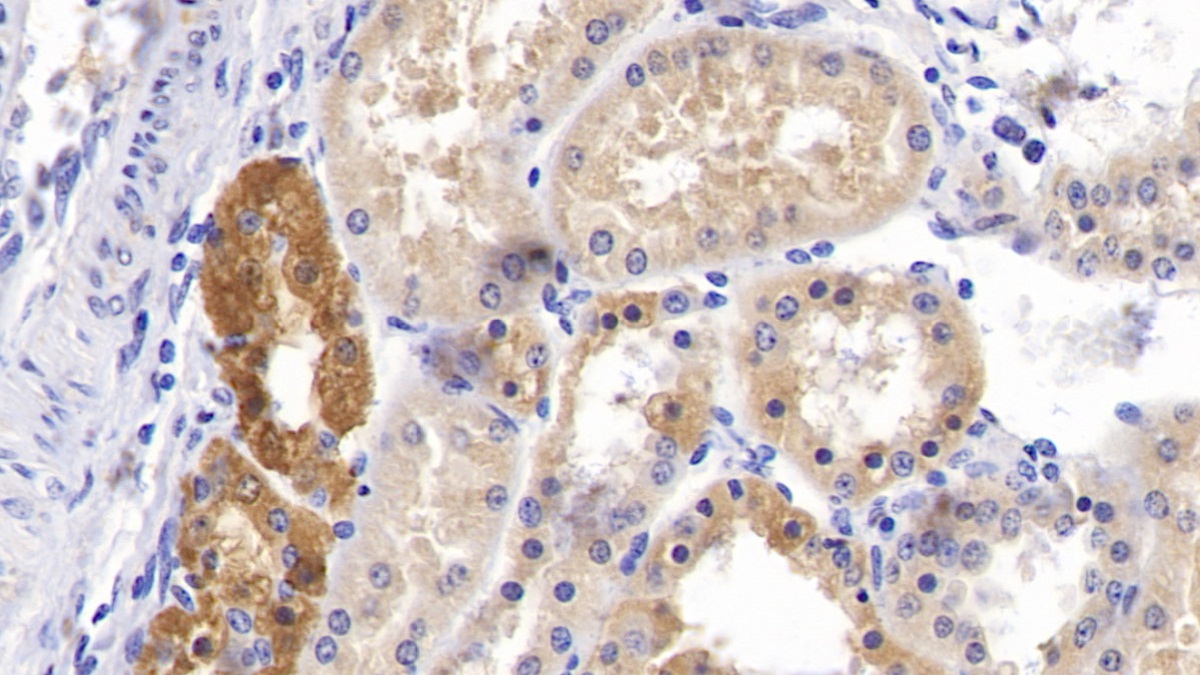

Polyclonal Antibody to Complement Factor B (CFB) 

CF-B; BF; BFD; CFAB; GBG; H2-Bf; PBF2; B-Factor; Properdin; Properdin factor B; C3/C5 convertase; Glycine-rich beta glycoprotein
Overview
Properties
- Product No.PAC011Hu02
- Organism SpeciesHomo sapiens (Human) Same name, Different species.
- ApplicationsWB,IHC
If the antibody is used in flow cytometry, please check FCM antibodies.
Research use only - DownloadInstruction Manual
- CategoryInfection immunityImmune moleculeHematologyAutoimmunity
- SourcePolyclonal antibody preparation, Host Rabbit
- Ig Type IgG, Potency n/a
- PurificationAntigen-specific affinity chromatography followed by Protein A affinity chromatography
- LabelNone
- Immunogen RPC011Hu02-Recombinant Complement Factor B (CFB)
- Buffer FormulationPBS, pH7.4, containing 0.01% SKL, 1mM DTT, 5% Trehalose and Proclin300.
- TraitsLiquid, Concentration 500µg/mL
Sign into your account
Share a new citation as an author
Upload your experimental result
Review

Contact us
Please fill in the blank.
Specifity
The antibody is a rabbit polyclonal antibody raised against CFB. It has been selected for its ability to recognize CFB in immunohistochemical staining and western blotting.
Usage
Western blotting: 0.2-2µg/mL;1:250-2500
Immunohistochemistry: 5-20µg/mL;1:25-100
Immunocytochemistry: 5-20µg/mL;1:25-100
Optimal working dilutions must be determined by end user.
Storage
Store at 4°C for frequent use. Stored at -20°C in a manual defrost freezer for two year without detectable loss of activity. Avoid repeated freeze-thaw cycles.
Stability
The thermal stability is described by the loss rate. The loss rate was determined by accelerated thermal degradation test, that is, incubate the protein at 37°C for 48h, and no obvious degradation and precipitation were observed. The loss rate is less than 5% within the expiration date under appropriate storage condition.
Giveaways
Increment services
-
 Antibody Labeling Customized Service
Antibody Labeling Customized Service
-
 Protein A/G Purification Column
Protein A/G Purification Column
-
 Staining Solution for Cells and Tissue
Staining Solution for Cells and Tissue
-
 Positive Control for Antibody
Positive Control for Antibody
-
 Tissue/Sections Customized Service
Tissue/Sections Customized Service
-
 Phosphorylated Antibody Customized Service
Phosphorylated Antibody Customized Service
-
 Western Blot (WB) Experiment Service
Western Blot (WB) Experiment Service
-
 Immunohistochemistry (IHC) Experiment Service
Immunohistochemistry (IHC) Experiment Service
-
 Immunocytochemistry (ICC) Experiment Service
Immunocytochemistry (ICC) Experiment Service
-
 Flow Cytometry (FCM) Experiment Service
Flow Cytometry (FCM) Experiment Service
-
 Immunoprecipitation (IP) Experiment Service
Immunoprecipitation (IP) Experiment Service
-
 Immunofluorescence (IF) Experiment Service
Immunofluorescence (IF) Experiment Service
-
 Buffer
Buffer
-
 DAB Chromogen Kit
DAB Chromogen Kit
-
 SABC Kit
SABC Kit
-
 Long-arm Biotin Labeling Kit
Long-arm Biotin Labeling Kit
-
 Real Time PCR Experimental Service
Real Time PCR Experimental Service
Citations
- Complement in patients receiving maintenance hemodialysis: functional screening and quantitative analysisBioMed: 14712369
- Identification and Confirmation of Differentially Expressed Fucosylated Glycoproteins in the Serum of Ovarian Cancer Patients Using a Lectin Array and LC–MS/MSACS: pr300330z
- Atypical hemolytic uremic syndrome: Korean pediatric seriesPubMed: 25443527
- Acute and prolonged complement activation in the central nervous system during herpes simplex encephalitisPubmed:27235358
- Adipose tissue complement factor B promotes adipocyte maturation.pubmed:29137982
- Serum exosomes from newborn piglets restrict porcine epidemic diarrhea virus infection
- Identification of susceptibility locus shared by IgA nephropathy and inflammatory bowel disease in a Chinese Han populationPubmed: 31857673
- Association between thrombotic microangiopathy and activated alternative complement pathway in malignant nephrosclerosis33367879
- Changes in complement alternative pathway components, factor B and factor H during dengue virus infection in the AG129 mouse33410734
- Early Diagnostic Ability of Human Complement Factor B in Pancreatic Cancer Is Partly Linked to Its Potential Tumor-Promoting Role34766501
- A Three-Protein Panel to Support the Diagnosis of Sepsis in ChildrenPubmed:35329889